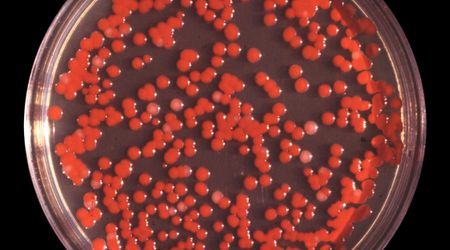

Biyolog
@biyolog
Join Date:
August 07, 2020
Publications:
1
Canlılığın Yapıtaşları: Hücreler, Koloniler
Koloniler, milyonlarca bireysel bakterilerden oluşan, bir ebeveynden geldikleri için genetik olarak birbirlerine benzeyen hücreler topluluğudur. Milyonlarca hüc
Views:
36
1/1